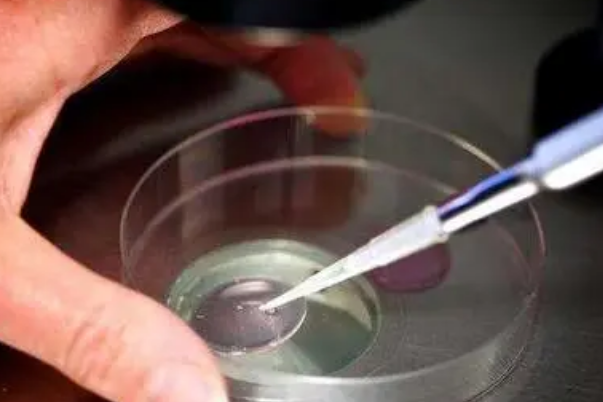
多次移植会导致成功率更低

因为每次移植失败后,子宫内膜和胚胎的质量可能都会受到影响,从而导致试管婴儿的成功率越来越低,其次,试管婴儿手术费用非常昂贵,对于家庭经济一般的人来说,多次尝试会增加经济负担。最后,频繁进行试管婴儿手术对大家的身体有一定伤害,因此,经历数次移植失败后,专家可能会建议大家慎重考虑,并不推荐继续进行试管婴儿手术。
试管移植是通过人工方法让卵细胞和精子在体外受精并进行胚胎发育,然后将胚胎移植到子宫内发育的一种授孕方式,对于一些移植了多次都没有成功怀上的女性来说,医生一般都会不建议大家再继续做这项手术,主要原因有下面三点:
1、多次移植后的成功率更低
女性年龄越大身体条件就会更差,试管婴儿成功的可能性一直都是在降低的。试管一次不成功,如果还要做,医生会根据具体的情况分析调整方案。而如果很多次都不成功,以后再做成功率会更低。
2、试管费用非常昂贵
试管婴儿的费用不菲,且很多时候一次成功的概率比较小,这不仅对身体有非常大的伤害,花费也是非常多的,一次至少要十万块,所以对于一般的家庭,这个费用是非常昂贵的,根本承担不起,如果连续失败好几次,那连家底都没有了。
3、多次试管会伤害身体
一般建议最多可做三次试管婴儿,因为女性每重新进行一次试管婴儿,就要再进行一次药物或针剂的前期准备,如服用促排卵的药物,但是这在一定程度上存在损害女性健康的风险,甚至会对女性造成不可逆的身体伤害。
总之,如果大家尝试了很多次试管手术都没有成功,医生通常会不在推荐大家再继续,此外,大家要注意保持良好的情绪,避免过度紧张,同时还要调理身体,可以多吃富含蛋白质的食物,如果出现不适症状,建议大家及时到正规医院就诊。


